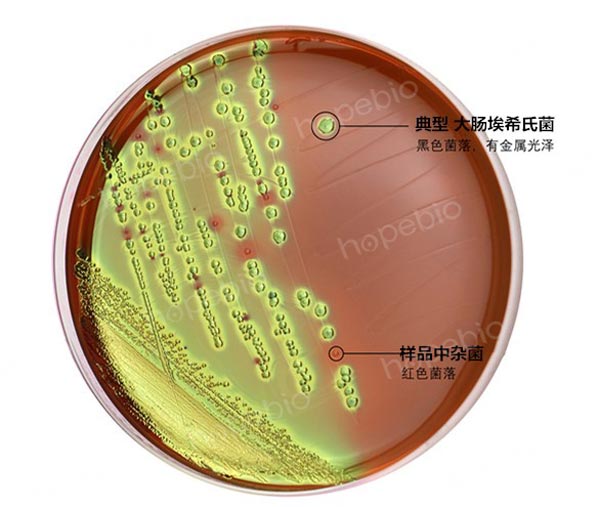
EMB培养不同菌株的试验结果（菌落黑色且有金属光泽的为大肠埃希氏菌）

海博微信公众号
海博微信公众号
 海博天猫旗舰店
海博天猫旗舰店


 海博微信公众号
海博微信公众号
 海博天猫旗舰店
海博天猫旗舰店




一、简介
大肠埃希氏菌(Escherichia coli),又叫大肠杆菌,是条件致病菌,在人体饮食不当或免疫力下降的时候可以引起胃肠道感染或尿道等多种局部组织器官感染,患者容易出现腹泻、腹痛、发烧等临床表现。
为了帮助更好地理解本文的操作,此处需要特别明确一下:大肠菌群并非细菌学分类命名,而是卫生细菌领域的用语,它不代表某一个或某一属细菌,而指的是具有某些特性的一组与粪便污染有关的细菌,这些细菌在生化及血清学方面并非完全一致,其定义为:需氧及兼性厌氧、在37℃能分解乳糖产酸产气的革兰氏阴性无芽孢杆菌。一般认为该菌群细菌可包括大肠埃希氏菌、柠檬酸杆菌、产气克雷伯氏菌和阴沟肠杆菌等。大肠菌群主要包括中希氏菌属、柠檬酸杆菌属、克雷伯氏菌属和肠杆菌属。
《GB4789.38 食品安全国家标准 食品微生物学检验 大肠埃希氏菌计数》中,有关大肠埃希氏菌的计数共涉及两种方法,MPN法和平板法,其中MPN法中对大肠埃希氏菌的分离主要分为三个步骤:初发酵试验、复发酵试验和平板分离试验(如图1)。
相关标准:GB 4789.38-2012 大肠埃希氏菌计数 -点击查看下载
本文主要对这些分离步骤进行解读和探讨。

图1 大肠埃希氏菌MPN计数法检验程序
二、培养基的选择与比较
为了有效分离出样品中的大肠埃希氏菌,标准中共选用了三种培养基,LST肉汤、EC肉汤和EMB琼脂。下面对这三种培养基全面进行比较(如表1)。
表1 大肠埃希氏菌分离用三种培养基的比较
|
比较 项目 |
液体发酵培养基 |
平板分离培养基 |
|||||||||||||||||||||||||||||||||||||||||||
|
初发酵 |
复发酵 |
划线平板 |
|||||||||||||||||||||||||||||||||||||||||||
|
名称 |
月桂基硫酸盐胰蛋白胨肉汤(LST肉汤) |
EC肉汤 |
EMB琼脂 |
||||||||||||||||||||||||||||||||||||||||||
|
货号 |
HB0102(干粉) |
HB0105(干粉) |
HB0107(干粉) |
||||||||||||||||||||||||||||||||||||||||||
|
HBKD0102/ HBKP0102(颗粒) |
HBKD0105/ HBKP0105(颗粒) |
HBKP0107(颗粒) |
|||||||||||||||||||||||||||||||||||||||||||
|
HBPT017(即用型试管) |
HBPT020-1(即用型试管) |
HBPM007(即用型平皿) |
|||||||||||||||||||||||||||||||||||||||||||
|
用途 |
用于大肠菌群、 大肠杆菌的测定 |
用于粪大肠菌群、 大肠杆菌的测定 |
用于分离肠道致病菌, 特别是大肠杆菌 |
||||||||||||||||||||||||||||||||||||||||||
|
配方(g/L) |
|
|
|
||||||||||||||||||||||||||||||||||||||||||
|
原理 |
乳糖提供菌体细胞生长所需要的碳源;月桂基硫酸钠抑制非大肠菌群类细菌的生长。 |
乳糖是可发酵的糖类;3号胆盐抑制革兰氏阳性菌,特别抑制革兰氏阳性杆菌和粪肠球菌。 |
乳糖作为可发酵的碳源;伊红和美蓝同时作为抑制剂和指示剂,在酸性条件下产生沉淀,形成具黑色中心有金属光泽或无光泽的菌落。 |
||||||||||||||||||||||||||||||||||||||||||
|
接种量 |
1mL |
1环 |
/ |
||||||||||||||||||||||||||||||||||||||||||
|
培养温度 |
36℃±1℃ |
44.5℃±0.2℃ |
36℃±1℃ |
||||||||||||||||||||||||||||||||||||||||||
|
培养时间 |
24h-48h |
24h-48h |
18h-24h |
||||||||||||||||||||||||||||||||||||||||||
|
阳性菌特征 |
浑浊度2,且气体充满管内1/3 |
浑浊度2,且气体充满管内1/3 |
黑色菌落,有金属光泽 |
||||||||||||||||||||||||||||||||||||||||||
|
排除菌 |
革兰氏阳性菌(粪肠球菌、金黄色葡萄球菌):抑制;沙门氏菌:生长,但不产气 |
革兰氏阳性菌(粪肠球菌、金黄色葡萄球菌):抑制;沙门氏菌-生长,但不产气;非大肠埃希氏菌的大菌群其它种类(柠檬酸杆菌、肠杆菌、克雷伯氏菌)-生长,但不产气 |
革兰氏阳性菌(粪肠球菌、金黄色葡萄球菌)-抑制;沙门氏菌-无色菌落;非大肠埃希氏菌的大菌群其它种类(柠檬酸杆菌、肠杆菌、克雷伯氏菌)-粉红色菌落,无金属光泽 |
||||||||||||||||||||||||||||||||||||||||||
|
可疑菌 |
大肠菌群(大肠埃希氏菌、柠檬酸杆菌、肠杆菌、产气克雷伯氏菌) |
大肠埃希氏菌 |
大肠埃希氏菌 |
||||||||||||||||||||||||||||||||||||||||||
三、程序解读和结果判断
从表中可以清晰地看出:该程序就是通过使用LST培养,将革兰氏阳性菌抑制住,并将非大肠菌群的其他细菌排除掉,有目的地筛选出大肠菌群细菌;然后通过使用EC肉汤培养,抑制革兰氏阳性细菌的同时,通过产气特征,进一步从大肠菌群中筛选出大肠埃希氏菌;然后将含有大量大肠埃希氏菌和少量杂菌的菌液进行EMB平板划线,彻底将大肠埃希氏菌培养成单菌落,通过菌落特征进行有效识别,方便后期进一步挑选、纯化和鉴定。
三个步骤中所用的培养基都能有效抑制革兰氏阳性菌的生长,所以完全不用担心这类细菌的干扰。
不同菌种在这三种培养基上的生长情况如图2所示:

图2-1 LST肉汤培养不同菌株的试验结果(浑浊且产气的为大肠菌群)

图2-2 EC肉汤培养不同菌株的结果(浑浊产气的为大肠埃希氏菌)
图2-3 EMB培养不同菌株的试验结果(菌落黑色且有金属光泽的为大肠埃希氏菌)
四、后续试验
通过逐步分离,形成的典型大肠埃希氏菌单菌落,并不能判定为就一定是大肠埃希氏菌,还需要将这些单菌落进一步纯化,进行后续的生化鉴定试验,才能最终确定是否为大肠埃希氏菌。
相关标准:
GB 4789.38-2012 大肠埃希氏菌计数 -点击标准下载
相关产品:
注:本文属海博生物原创,未经允许不得转载。
| 相关文章: | ||



